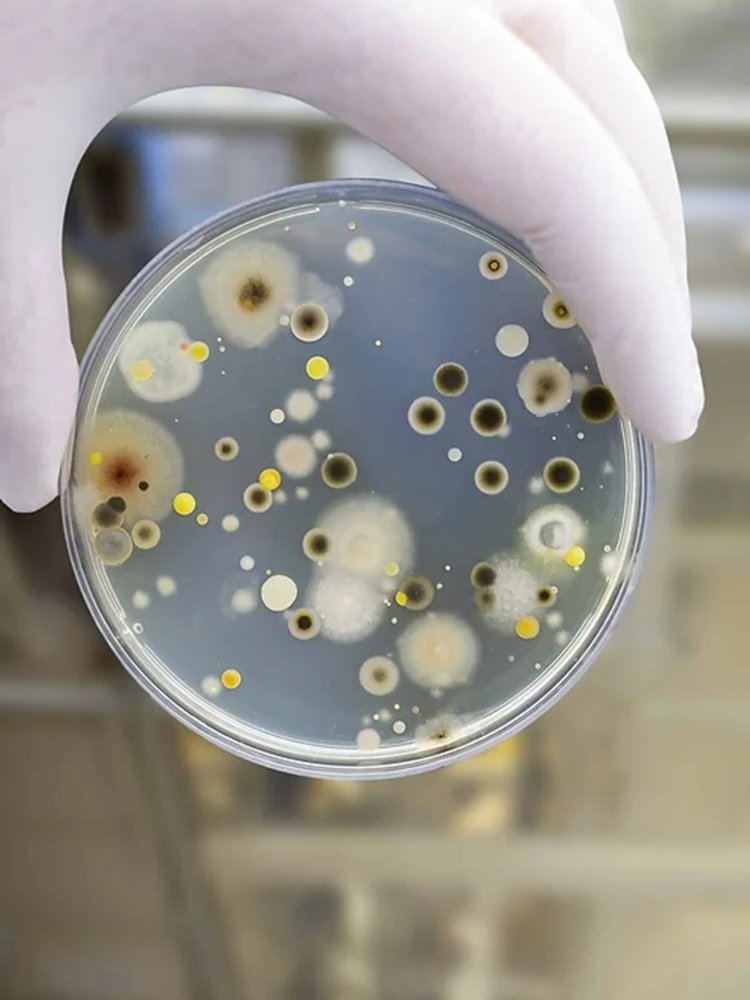
Mold

Professional Mold Removal
Right Coast Solutions offers expert mold removal and prevention across Eastern North Carolina—safe, fast, and reliable solutions to protect your home and health.
Residential
Commercial
Remodeling
One-time Cleaning
Regular Cleaning
Housekeeping
Full Service Residential & Commercial Mold Removal & Prevention
Lorem ipsum dolor sit amet, consectetur adipiscing elit, sed do eiusmod tempor incididunt ut labore et dolore magna aliqua. Ut enim ad minim veniam, quis nostrud exercitation ullamco laboris nisi ut aliquip ex ea commodo consequat.
Trusted & Experienced
Lorem ipsum dolor sit amet, consectetur adipiscing elit, sed do eiusmod tempor incididunt ut
No Contracts
Lorem ipsum dolor sit amet, consectetur adipiscing elit, sed do eiusmod tempor incididunt ut
Reliable & Fully Insured
Lorem ipsum dolor sit amet, consectetur adipiscing elit, sed do eiusmod tempor incididunt ut
Satisfaction Guaranteed
Lorem ipsum dolor sit amet, consectetur adipiscing elit, sed do eiusmod tempor incididunt ut
Other Services
Carpet Cleaning
Window Cleaning
Outdoor Furniture
Laundry Services
Trash Removal
Dish Washing
Move In & Out Cleaning
Dry Cleaning
Appliance Deep Clean

Happy Customers
Contact us
F.A.Q.
Mauris blandit aliquet ipsum dolor amet sit?
Nulla quis lorem ut libero malesuada feugiat. Praesent sapien massa, convallis a pellentesque nec, egestas non nisi. Mauris blandit aliquet elit, eget tincidunt nibh pulvinar a. Praesent sapien massa, convallis a pellentesque nec, egestas non nisi.
Curabitur aliquet quam id dui posuere blandit?
Nulla quis lorem ut libero malesuada feugiat. Praesent sapien massa, convallis a pellentesque nec, egestas non nisi. Mauris blandit aliquet elit, eget tincidunt nibh pulvinar a. Praesent sapien massa, convallis a pellentesque nec, egestas non nisi.
Mauris blandit aliquet ipsum dolor amet sit?
Nulla quis lorem ut libero malesuada feugiat. Praesent sapien massa, convallis a pellentesque nec, egestas non nisi. Mauris blandit aliquet elit, eget tincidunt nibh pulvinar a. Praesent sapien massa, convallis a pellentesque nec, egestas non nisi.
Nulla quis lorem ut libero malesuada feugiat?
Nulla quis lorem ut libero malesuada feugiat. Praesent sapien massa, convallis a pellentesque nec, egestas non nisi. Mauris blandit aliquet elit, eget tincidunt nibh pulvinar a. Praesent sapien massa, convallis a pellentesque nec, egestas non nisi.
Mauris blandit aliquet elit eget tincidunt nibh pulvinar ?
Nulla quis lorem ut libero malesuada feugiat. Praesent sapien massa, convallis a pellentesque nec, egestas non nisi. Mauris blandit aliquet elit, eget tincidunt nibh pulvinar a. Praesent sapien massa, convallis a pellentesque nec, egestas non nisi.
Sapien massa convallis a pellentesque nec egestas non nisi?
Nulla quis lorem ut libero malesuada feugiat. Praesent sapien massa, convallis a pellentesque nec, egestas non nisi. Mauris blandit aliquet elit, eget tincidunt nibh pulvinar a. Praesent sapien massa, convallis a pellentesque nec, egestas non nisi.
(252) 342-5363
Book a Cleaning or Customize a Plan Today
